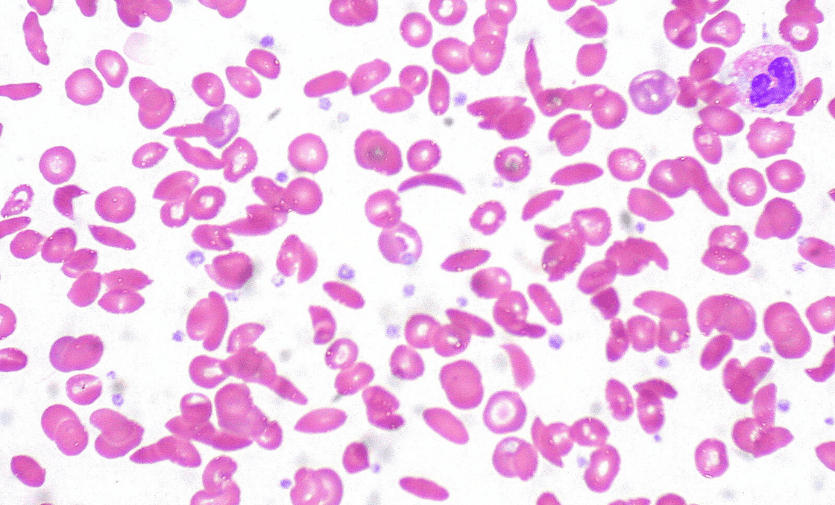
Sickle cell disease is caused by a mutation in the gene that produces haemoglobin, the protein that carries oxygen in red blood cells.

25/02/26
Breakthrough sickle cell gene therapy a distant hope in Africa
By: Johnnie Musenze
Send to a friend
The details you provide on this page will not be used to send unsolicited email, and will not be sold to a 3rd party. See privacy policy.
[KAMPALA, SciDev.Net] As Uganda rolls out mandatory nationwide screening of newborns for sickle cell disease this month, a gene therapy celebrated in the United States and Europe remains financially out of reach for most patients in Africa.
Ayoola Olajide, president of Ikorodu Sickle Cell Club in Nigeria and a person living with sickle cell disease, told SciDev.Net: “For Africa, gene therapy treatment currently exists only on paper.”
According to the World Health Organization, about 515,000 babies are born each year with sickle cell disease, a lifelong, inherited blood disorder. Around 80 per cent of cases occur in Sub-Saharan Africa, where it is a leading cause of deaths among young children.
“Yes, gene therapy brings hope but it’s a hope that’s almost impossible for our people because of the cost.””
Elisha Osati, chairman, Tanzania Sickle Cell Disease Alliance
In Uganda, the Ministry of Health launched a policy this month (9 February) requiring all babies born in health facilities to be screened for the disease at birth, free of charge, in a bid to reduce preventable deaths.
Official figures show an estimated 20,000 Ugandan children are born with the condition each year, with up to 80 per cent dying before the age of five, largely due to delayed diagnosis and preventable complications.
Gene-editing ‘milestone’
While African governments expand early detection and basic treatment, high-income countries have been adopting the first approved gene-editing therapy designed to cure sickle cell disease.
The United States Food and Drug Administration approved Casgevy (exagamglogene autotemcel) for patients aged 12 years and over in December 2023, hailing it a “milestone” treatment. The UK Medicines and Healthcare products Regulatory Agency approved the therapy weeks earlier and it was authorised for use in the National Health Service in England in January this year.
The FDA also approved Lyfgenia, a cell-based gene therapy manufactured by Bluebird Bio, though it comes with a warning of possible cancer risks.
Sickle cell disease is caused by a mutation in the gene that produces haemoglobin, the protein that carries oxygen in red blood cells. The defect causes cells to become rigid and “sickle” shaped, leading to severe pain, organ damage and shortened life expectancy.
Casgevy works by taking a patient’s blood stem cells, editing them in the laboratory using CRISPR gene-editing technology to reactivate healthy haemoglobin production, and then reinfusing them into the body after chemotherapy. If successful, the patient begins producing functional red blood cells.
Clinical trials showed the therapy dramatically reduced severe pain episodes in most patients treated.
Hefty price tag
However, the breakthrough comes with a staggering cost, with Casgevy priced at around US$2.2 million in the United States.
The manufacturer, Vertex, did not respond to SciDev.Net’s questions about pricing for low- and middle-income countries. Bluebird Bio also didn’t provide a response ahead of publication.
For Olajide, the price tag for gene therapy makes it largely symbolic in Nigeria, a country where many families can’t even afford basic medicines.
“It gives hope but not much hope,” he said.
“You must be extremely wealthy to even think about it and I know 99 per cent of the Nigerians cannot afford it so it’s of no use to many.”
Nigeria carries the world’s largest burden of sickle cell disease, with an estimated 150,000 babies born with the condition each year. Millions more live with the disorder and many lack access to consistent treatment.
Bone marrow transplants
For decades, treatment in Africa has focused on managing symptoms through pain relief, infection prevention, blood transfusions and, in limited cases, bone marrow transplants—previously the only established cure.
Peripheral blood smear showing sickle in red blood cells due to poor oxygen supply. Image credit: Ed Uthman/Flickr
Nigeria has established three bone marrow transplant centres offering this treatment. However, costs range from US$50,000 to over US$200,000, making that also unaffordable for most families.
Trust is another barrier. Even when procedures are available at home, many prefer to seek treatment abroad if they can afford it.
Elisha Osati, chairman of the Tanzania Sickle Cell Disease Alliance, said gene therapy’s advantage over bone marrow transplantation is that it does not require a donor—an important consideration for African patients, who face lower donor match rates globally. He believes treatment must be made accessible.
“Yes, gene therapy brings hope but it’s a hope that’s almost impossible for our people because of the cost,” said Osati.
“What we need now is collaboration, to train our scientists so that such technology can be transferred to Africa.”
Sophisticated technology
Lois Bayigga, a research scientist at Uganda’s Joint Clinical Research Centre, said gene therapy prices reflect both the complexity of the science and the infrastructure required to deliver it.
“Most gene therapy today relies on viral vectors and requires highly specialised, good manufacturing practice facilities that cost millions of dollars to build, so companies sell these therapies at an extremely high price to recover the costs incurred,” she said.
Although Casgevy does not rely on viral delivery systems, it still requires sophisticated laboratory processes and highly controlled facilities.
“If viral vectors and gene therapy components were manufactured locally, pricing would drop significantly,” Bayigga said.
“There are emerging models that show gene therapy work can be done in simpler labs.”
Bayigga is currently working on a simplified manufacturing workflow that could potentially be implemented in settings like Uganda.
“This is how we begin to imagine gene therapy that is realistic for low- and middle-income countries,” she added.
Investing in testing
Advocates stress that while gene therapy is causing a buzz in wealthy countries, African governments must prioritise prevention, screening and accessible treatment.
Africa has the highest burden of inherited blood disorders globally, Bayigga noted.
“Our governments should be the biggest investors and advocates for African-led solutions to African problems,” she said.
Olajide added: “Our government needs to focus more on prevention for now. We need to make sure our people can access testing centres, just like you see HIV testing.”
Uganda’s mandatory newborn screening policy reflects that strategy, expanding early diagnosis and ensuring immediate initiation of lifelong medication where needed.
However, Bayigga warned that celebrating cures without addressing access will only deepen inequalities.
“All lives have equal value,” she added.
“If a cure exists but is inaccessible, that is inequality. It creates hope for some, but pain for others who know they will never access it.”
This piece was produced by SciDev.Net’s Sub-Saharan Africa English desk.
